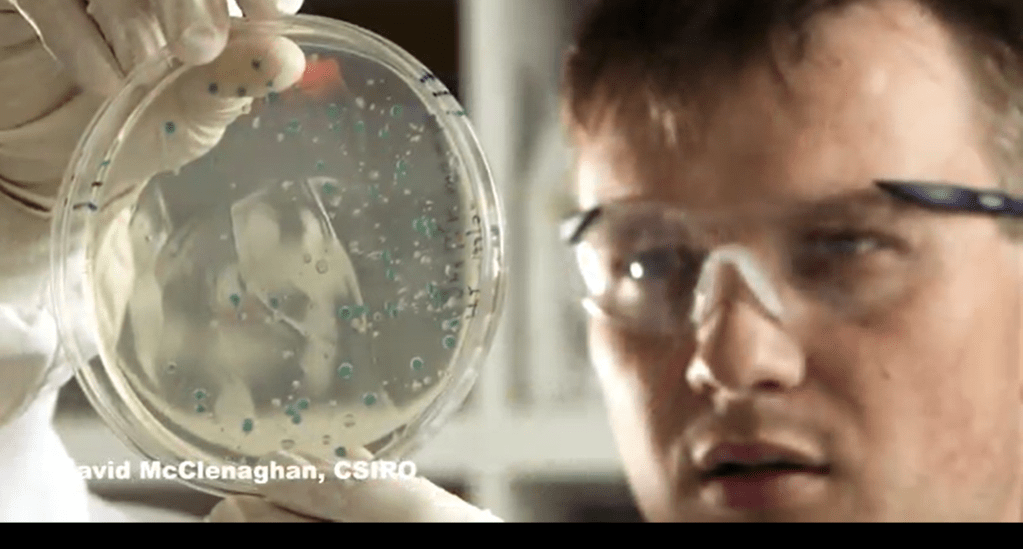

Hi guys, welcome to the 30 lecture ofthe course Biological Diversity Theories, Measures and Data sampling techniques. Today, I will explain you the sampling techniques to analyze and measure biodiversity.
There are different samplic techniques,we start to analyze the terrestrial vertebrae, so the first thingthat is very important to know is the species target, soif you are studying rare, etc. So, second thing you need toknow is the taxonomy, and the classification on these species. It means that if you wantto study biodiversity, you need to identify species. If you cannot do directly,you can ask some expert to do it for you. There are different methods tosampling terrestrial vertebrates.

There are direct observation orindirect observation. In the direct observation,you use your naked eyes, binoculars, or other equipment.

In the indirect observation, you just follow tracks you recognize, footprints, songs, calls etc.

There are standardized sampling method you can use trapping for instance. There’s no killing traps forsmall mammals, or pitfall traps. Pitfalls traps are traps that are hidden in the ground and animals just fall down.

To sample bugs and birds, usuallyare adopted direct observation methods, or net observation methods. So, it means that nets are building in some special places that are random,for instance. And are collected inside, identified, and released.


There are other methods for mammals, for rodents, for instance, such as sampling tubes that just collect hairs of the animals and allow them to recognize the animals. Or, for instance, we can use howling and calls. In this case, we just send a howling of a specific species such as a wolf for instance, andthey will recognize their call.

For tortoise, we can use traps. For birds of prey, for instance, we can use to recognize pellets and bones that are inside these pellets. This is an indirect method that’s very useful to identify species that are not easy to spot directly.

The modern technology provides a new technique to understand which species leaving a territory. For instance, photo trapping. Photo trapping used camera in a remote way. So, you place the camera, then you wait the night for instance and go back. This camera has a kind of infrared sensor that catches animals, and then when they pass through, they just get photo of them, and then you can recognize what species live in that place.

Radiotelemetry is another system. In this case, this system is more useful if you are following The same species of the same individuals a long time. So, you use antenna’s to monitor the movements of the species.

Ranking and marking is another system, usually use this for birds. In this case, you can mark and recapture these animals to understand the dimension of the population.
Nest counting is a another system to monitor birds in this case.

For aquatic vertebrates,there are other sampling methods. One of these is direct method to recognizeand to identify species of whales, that’s whale watching,that you can easily do from a boat

Plankton nets are just nets that you use to collect plankton. They have a very thinly metric. So, you can use dense metrics varies more to correct all plankton you’re interested in.

Dragnets are on the system. These dragnets are that move onthe bottom, or the sea side, and then you correct species from the ground deep net, deep nets are similarnets that go even deeper. And in this case, you can collect species.

Radio detectors, radio detectors are very useful. if you want to understand, indirectly, which species, for instance, whales or dolphins, live in a certain place. And in this way, you can understand which species this is based on the sounds they are emitting, their calls.


There are also cages. Cages are very useful when you want to trap animals. In this case, you just drop, you wait,you go identify your stand back. Rovers, that’s a very important technology that’s been developed. So, these rovers are radio commanded. You can use them to go in the deep sea. While you cannot understand which species are there without going with the submarines, orsome other equipment like that. So, robots are very useful. There are, of course, systems that are more easy that are our on board monitoring easier system that you can just follow just along your trip.
And less counting for turtles, for instance, you can walk along sea side and count the number of nest. On nest, that are tortoise are placing some techniques for vertebrae include different meters. For example, direct observation, of course, but are usually very difficult, because it’s not easy to observe that directly the species you want to identify. More species are very similar to each other. Even butterflies that are socolored seems to be so easy to identify, it needs a deep knowledge of the species.

So, you use pitfall traps, nets, light traps for most, for instance, lure traps. Or soil samples, soil samples if you want to understand what is there, found in the soil, orsometimes the number of seeds, or species are in the seeds or in the soil.


Technical logical umbrellais very similar to a normal umbrella when you put under trees,for instance, you shake the tree and old animals fall down, and you can collect these animals inside the umbrella. The is a simple tent, is like a camping tent. That is open everywhere, but there is some that surround so animals can go inside from one side and enter inside this kind of tent, and you catch and collect the animal there you can identify.


There are other systems like a bottle with funnel, winker trap, minskin bottle. All these system use special traps with lights or with nets or small magic nets, just to trap small, tiny animals and collect them, waiting for when you are back to identify them.

There are other systems such as trap, samples that collect sample of mud or on the ground and then you can identify species that are already inside.
A very simple system that just easy to identify above ground species is the sampling squares. You just put the squares and then you count the number of individual species that are inside.


To sample vascular plants, usually weuse plots, quadrants, or transits. As I told you, a plot is justa simple space that we identify a and then we put randomly over the area that we want to analyze, or study the area.
Quadrants are very similar, butare very useful to identify and to collect samples andspecies in small parcel. We use quadrants for plants, for instance, but not for trees. Transects are very useful when you want to put a straight line and follow this line and identify what this there along this line.

Usually it’s very important to set a priority. A kind of minimum that is diameter or the brass square. At the bird’s eye,when you can set what’s the limit of your sampling because sometimes you want to collect all species that have a DBH, or a diameter more than five centimeters,or more than ten. So, it’s better to specify in your papers when you report your results which kind of diameter, meaning a diameter you are using when you collect species of tree species.

When you want to sample fires, fungi, Lycus and osmosis you use quadrants in the ground. I told you this is very useful for small space that you can easily identify in small places. For instance, you can use this quad that’son the trunk of the trees to identify mosses on the ground, on the grasses, over the stones. That depends on which kind, which group, what’s your target group.
Are very useful in this case. You can put random at the distance of fixed. For instance, average two meters, so, a random distance. So, you put your is random decided by factors.

And another very useful anduseful equipment in this case is the lens. You need to some lenses, small microscopes, portal microscope.
Just to identify better, the species that sometimes need a very accurate identification to monitor,and to sample micro organisms. There are different systems. Of course, you cannot do this type with your own naked eyes.
So, you need for instance petri dishes where you can grow these species. So, you need to grow terrains, or while you can, of course, allow this species to develop to identify better. And you need microscopes if you want to identify invertebrates, micro-invertebrates of water for instance. You can not identify that with the naked eye, so you need this special instrument. So, you need to collect your samples, to grow a laboratory, to identify these species. Of course, this is very specialist work, you need very expert in doing this.

And the last system that I want to show you is a system that has been developed recently. And it is very interesting because it involves many people and many groups. In the society. It’s called Bio Bliss. Bio Bliss is a 24 hour in which teams of volunteer scientists, families, students, teachers and other community members work together to find and identify as many species of plants, animals and microbes, fungi, etc andother organisms as possible. I hope that this general overview of sampling meters for sampling species, in case you want to analyse biological diversity, will help you in the ground to monitor it, sample species. I’ll see you next time.
Legg igjen en kommentar